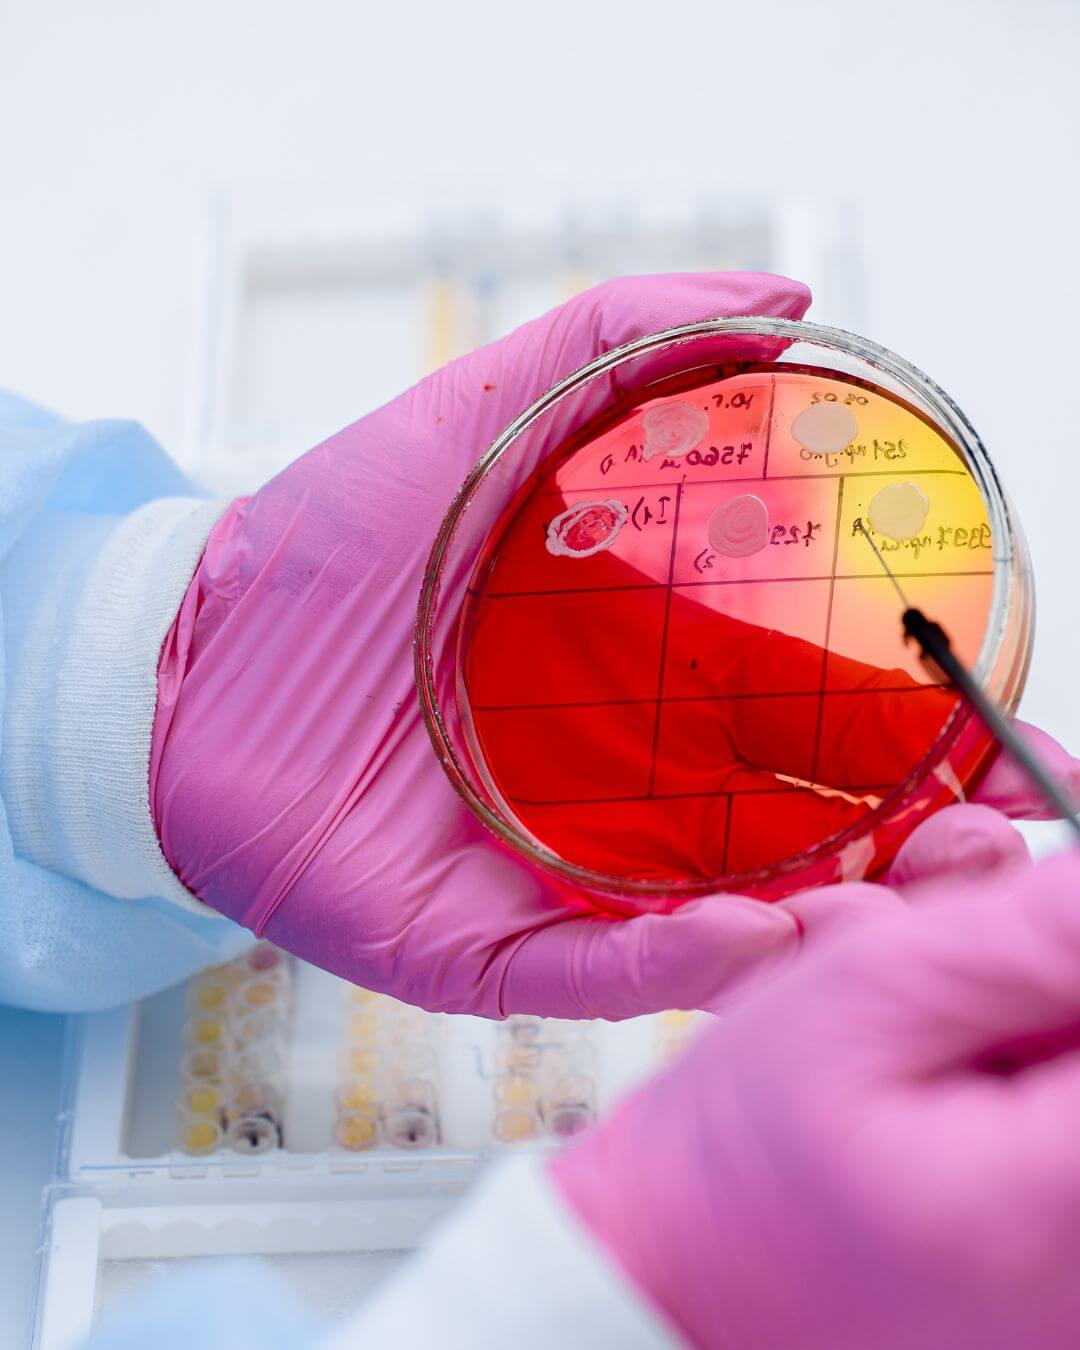
ernährungscoaching mit nadine

Finde Schritt für Schritt zurück zu einer Ernährung
die deinem Bauch Ruhe schenkt und dir neue Energie gibt

Das Ernährungscoaching ist eine 1:1 Begleitung, die dir hilft, deine Ernährung so zu gestalten, dass sie:

deinem Bauch gut tut

Meine Vision ist, dass du wieder Vertrauen in deinen Körper findest und Essen nicht länger mit Unsicherheit, sondern mit Freude verbindest.
Dein Alltag rund um deine Ernährung ist eine Herausforderung:

Sehnst du dich nach einem Alltag, in dem dein Bauch nicht mehr ständig im Mittelpunkt steht?

Hast du schon vieles ausprobiert Diäten, Medikamente oder Tipps aus dem Internet und trotzdem bleiben die Beschwerden?

Wünschst du dir, wieder mit Freude und ohne Unsicherheit am Familientisch sitzen zu können?

Wie würde es sich für dich anfühlen, wenn du in einem Jahr mit mehr Energie, Ruhe im Bauch und Vertrauen in deinen Körper durchs Leben gehst?

Möchtest du endlich verstehen, was dein Bauch dir sagen will und lernen, liebevoll darauf zu reagieren?

Nadine Camenzind
Ich bin Nadine, ganzheitliche Darmtherapeutin und Ernährungsberaterin. Mein Weg war alles andere als gerade – geprägt von eigenen Verdauungsproblemen, einer Magenoperation und der Suche nach Antworten. Deshalb weiß ich, wie belastend es ist, wenn der Bauch den Alltag bestimmt.
Darum habe ich mein Wissen vertieft: Ernährungsberatung, Darmtherapie, Naturheilkunde, Blut- und Stuhldiagnostik sowie Methoden wie klassische Massage und Mikronährstoffe. Heute verbinde ich diese Expertise mit meiner eigenen Geschichte und begleite Menschen auf eine Art, die im echten Leben funktioniert.
Ich erkläre komplexe Themen leicht verständlich, damit du verstehst, was in deinem Körper passiert. Meine Kund:innen schätzen, dass sie sich bei mir gesehen und ernst genommen fühlen – weil ich nicht nur Symptome, sondern den ganzen Menschen im Blick habe.
Was mich qualifiziert, dich in deiner Ernährungsreise zu begleiten:

Darmtherapie
und Naturheilkunde

mit Magenoperation, Verdauungsproblemen, Unverträglichkeiten

Mein Herz für Menschen
die endlich Klarheit, Sicherheit und Leichtigkeit im Alltag mit ihrem Bauch suchen.
Durch Ernährungscoaching verändert sich
einiges in deinem Leben:
Im Moment fühlst du dich:

Dir fehlt die Sicherheit, welche Lebensmittel deinem Bauch gut tun und welche Beschwerden auslösen.

Du möchtest endlich ohne Angst essen, ohne danach Blähungen, Schmerzen oder Durchfall zu bekommen.

Du willst verstehen, warum Diäten, Medikamente oder Ratschläge bisher nicht die gewünschte Wirkung hatten.

Dir fehlt die Energie, weil dein Körper die Nahrung nicht optimal verwertet und du wünschst dir neue Kraft im Alltag.

Du möchtest zurück zu Genuss und Freude beim Essen, statt ständig das Gefühl zu haben, verzichten zu müssen.
Das verändert sich für dich:

Du gewinnst Klarheit und Sicherheit, welche Lebensmittel dir gut tun, endlich ohne ständiges Rätselraten.

Essen wird wieder entspannt und genussvoll, statt mit Angst oder Unsicherheit verbunden zu sein.

Dein Bauch kommt zur Ruhe, Blähungen und Beschwerden lassen nach. Du fühlst dich leichter im Alltag.

Du spürst neue Energie, weil dein Körper besser versorgt ist und du dich wohler fühlst.

Du gehst gestärkt und selbstbewusst durchs Leben, weil du weisst, wie du mit deinem Bauch umgehen kannst.










So gestaltet sich dein Ernährungscoaching
Damit du genau weisst, was dich erwartet, habe ich mein Ernährungscoaching für dich in klare Schritte und Inhalte aufgeteilt:

01.
Persönliches Kennenlernen
Wir starten mit einem ausführlichen Gespräch, in dem du mir deine Beschwerden, deine Ernährung und deine bisherigen Erfahrungen schilderst. So entsteht ein erstes Bild von dir und deinem Bauch, die Basis für unsere Zusammenarbeit.
02.
Individuelle Analyse
Gemeinsam schauen wir, welche Faktoren für deine Beschwerden eine Rolle spielen könnten. Dazu können: deine Ernährung, dein Lebensstil oder, wenn vorhanden, Labor- oder Stuhlergebnisse gehören. Du bekommst von mir klare, verständliche Erklärungen und kleine Bilder im Kopf, damit du sofort nachvollziehen kannst, was in deinem Körper passiert.

03.
Dein persönlicher Ernährungsfahrplan

welche Lebensmittel dich entlasten


wie du trotz Unverträglichkeiten, Operation oder sensiblen Bauch genussvoll essen kannst

04.
Praktische Umsetzung im Alltag
Du bekommst einfache Tipps und Tools, die du sofort umsetzen kannst, Schritt für Schritt.
Egal ob Rezepte, Ideen für Snacks oder kleine Routinen: ich zeige dir Wege, die auch in einen vollen Alltag passen.

05.
Begleitung & Anpassung
Während der Zusammenarbeit stehe ich dir zur Seite, beantworte deine Fragen und passe den Plan an, sobald sich dein Bauch verändert.
Denn jeder Körper reagiert individuell und wir bleiben flexibel.

06.
Nachhaltige Stärkung
Mein Ziel ist, dass du auch nach unserer Zeit selbstbewusst und sicher mit deinem Bauch umgehen kannst. Du wirst verstehen, was dir gut tut, wie du Beschwerden vorbeugst und wie du langfristig Freude am Essen behältst.
Mehr Ruhe im Bauch, weniger Unsicherheit und ein Alltag, in dem Essen wieder Kraft und Freude schenkt.

Deine Vorteile im Ernährungscoaching
Schon nach kurzer Zeit …

Du spürst erste Entlastung im Bauch – weniger Blähungen, weniger Unsicherheit nach dem Essen.

Du gewinnst Sicherheit und Klarheit, welche Lebensmittel für dich gut sind und welche nicht.

Dein Alltag wird entspannter, weil du endlich weisst, was du essen kannst, ohne Angst vor Beschwerden.

Du baust ein neues Vertrauen in deinen Körper auf und lernst seine Signale besser zu verstehen.

Du findest zurück zu Genuss und Freude beim Essen, ohne ständigen Verzicht oder Schuldgefühle.

Dein Bauch kommt mehr und mehr ins Gleichgewicht und mit ihm dein gesamtes Wohlbefinden, deine Energie und deine Lebensqualität.
Deine Bonus-Inhalte im Ernährungscoaching

Individuelle Handouts & Übersichten
Klare, leicht verständliche Unterlagen zu Ernährung, Verdauung und Alltagstipps, die du jederzeit nachlesen kannst.

Einfache Rezeptideen
Schnell umsetzbar, bauchfreundlich und alltagstauglich, damit du sofort Sicherheit beim Kochen hast.

Achtsamkeits-Impulse
Kleine Übungen und Rituale, die dich unterstützen, entspannter zu essen und wieder mehr auf dein Bauchgefühl zu hören.

Persönlicher Support
Die Möglichkeit, dich bei Fragen zwischen den Terminen kurz bei mir zu melden, damit du dich nicht allein fühlst.

Naturheilkundliche Empfehlungen
Inspirationen aus Pflanzenheilkunde, Bitterstoffen oder kleinen Anwendungen, die dein Wohlbefinden zusätzlich stärken.
So einfach kommst du zur Zusammenarbeit
1. Kontakt aufnehmen
Fülle einfach das Kontaktformular auf meiner Website aus oder buche direkt einen unverbindlichen Termin über das Buchungssystem. So erfahre ich schon ein wenig über dich und dein Anliegen.
2. Kennenlerngespräch
In einem unverbindlichen Erstgespräch lernen wir uns kennen. Du erzählst mir von deinen Beschwerden, deiner Situation und deinen Zielen und wir klären, ob und wie ich dich unterstützen kann.
3. Entscheidung & Buchung
Wenn es für dich passt, buchst du dein Ernährungscoaching ganz unkompliziert. Du bekommst alle wichtigen Informationen, Unterlagen und den Ablauf transparent von mir zugeschickt.
4. Start deiner Begleitung
Wir vereinbaren deinen ersten Termin. Ab jetzt gehen wir Schritt für Schritt deinen Weg mit Klarheit, Empathie und einem Plan, der zu dir und deinem Bauch passt.
Häufige Fragen zum Ernährungscoaching:
Wie läuft das Ernährungscoaching ab?

Wir starten mit einem ausführlichen Erstgespräch, in dem du mir deine Beschwerden und Ziele schilderst. Danach erhältst du von mir einen klaren, alltagstauglichen Fahrplan mit Ernährungstipps, einfachen Umsetzungen und ganzheitlichen Impulsen. Schritt für Schritt begleite ich dich dabei, deinen Bauch zu entlasten und mehr Sicherheit zu gewinnen.
Muss ich vorher schon Labor- oder Stuhlergebnisse haben?

Ist das Coaching auch nach einer Magenoperation geeignet?

Kann ich das Coaching auch online machen?

Wie schnell sehe ich Ergebnisse?

Jeder Körper reagiert individuell. Manche spüren bereits nach wenigen Wochen eine deutliche Entlastung, bei anderen dauert es etwas länger.
Wichtig ist: wir gehen Schritt für Schritt, in deinem Tempo damit die Veränderungen nachhaltig sind.
Was ist, wenn ich zwischendurch Fragen habe?

Während unserer Zusammenarbeit bin ich für dich da. Kleinere Fragen zwischen den Terminen kannst du mir gerne stellen so fühlst du dich nie allein gelassen.
Mein Ziel: Dass du dich von Anfang an gut aufgehoben fühlst und genau weisst, was dich erwartet ohne Überraschungen, aber mit viel Herz und Klarheit.

